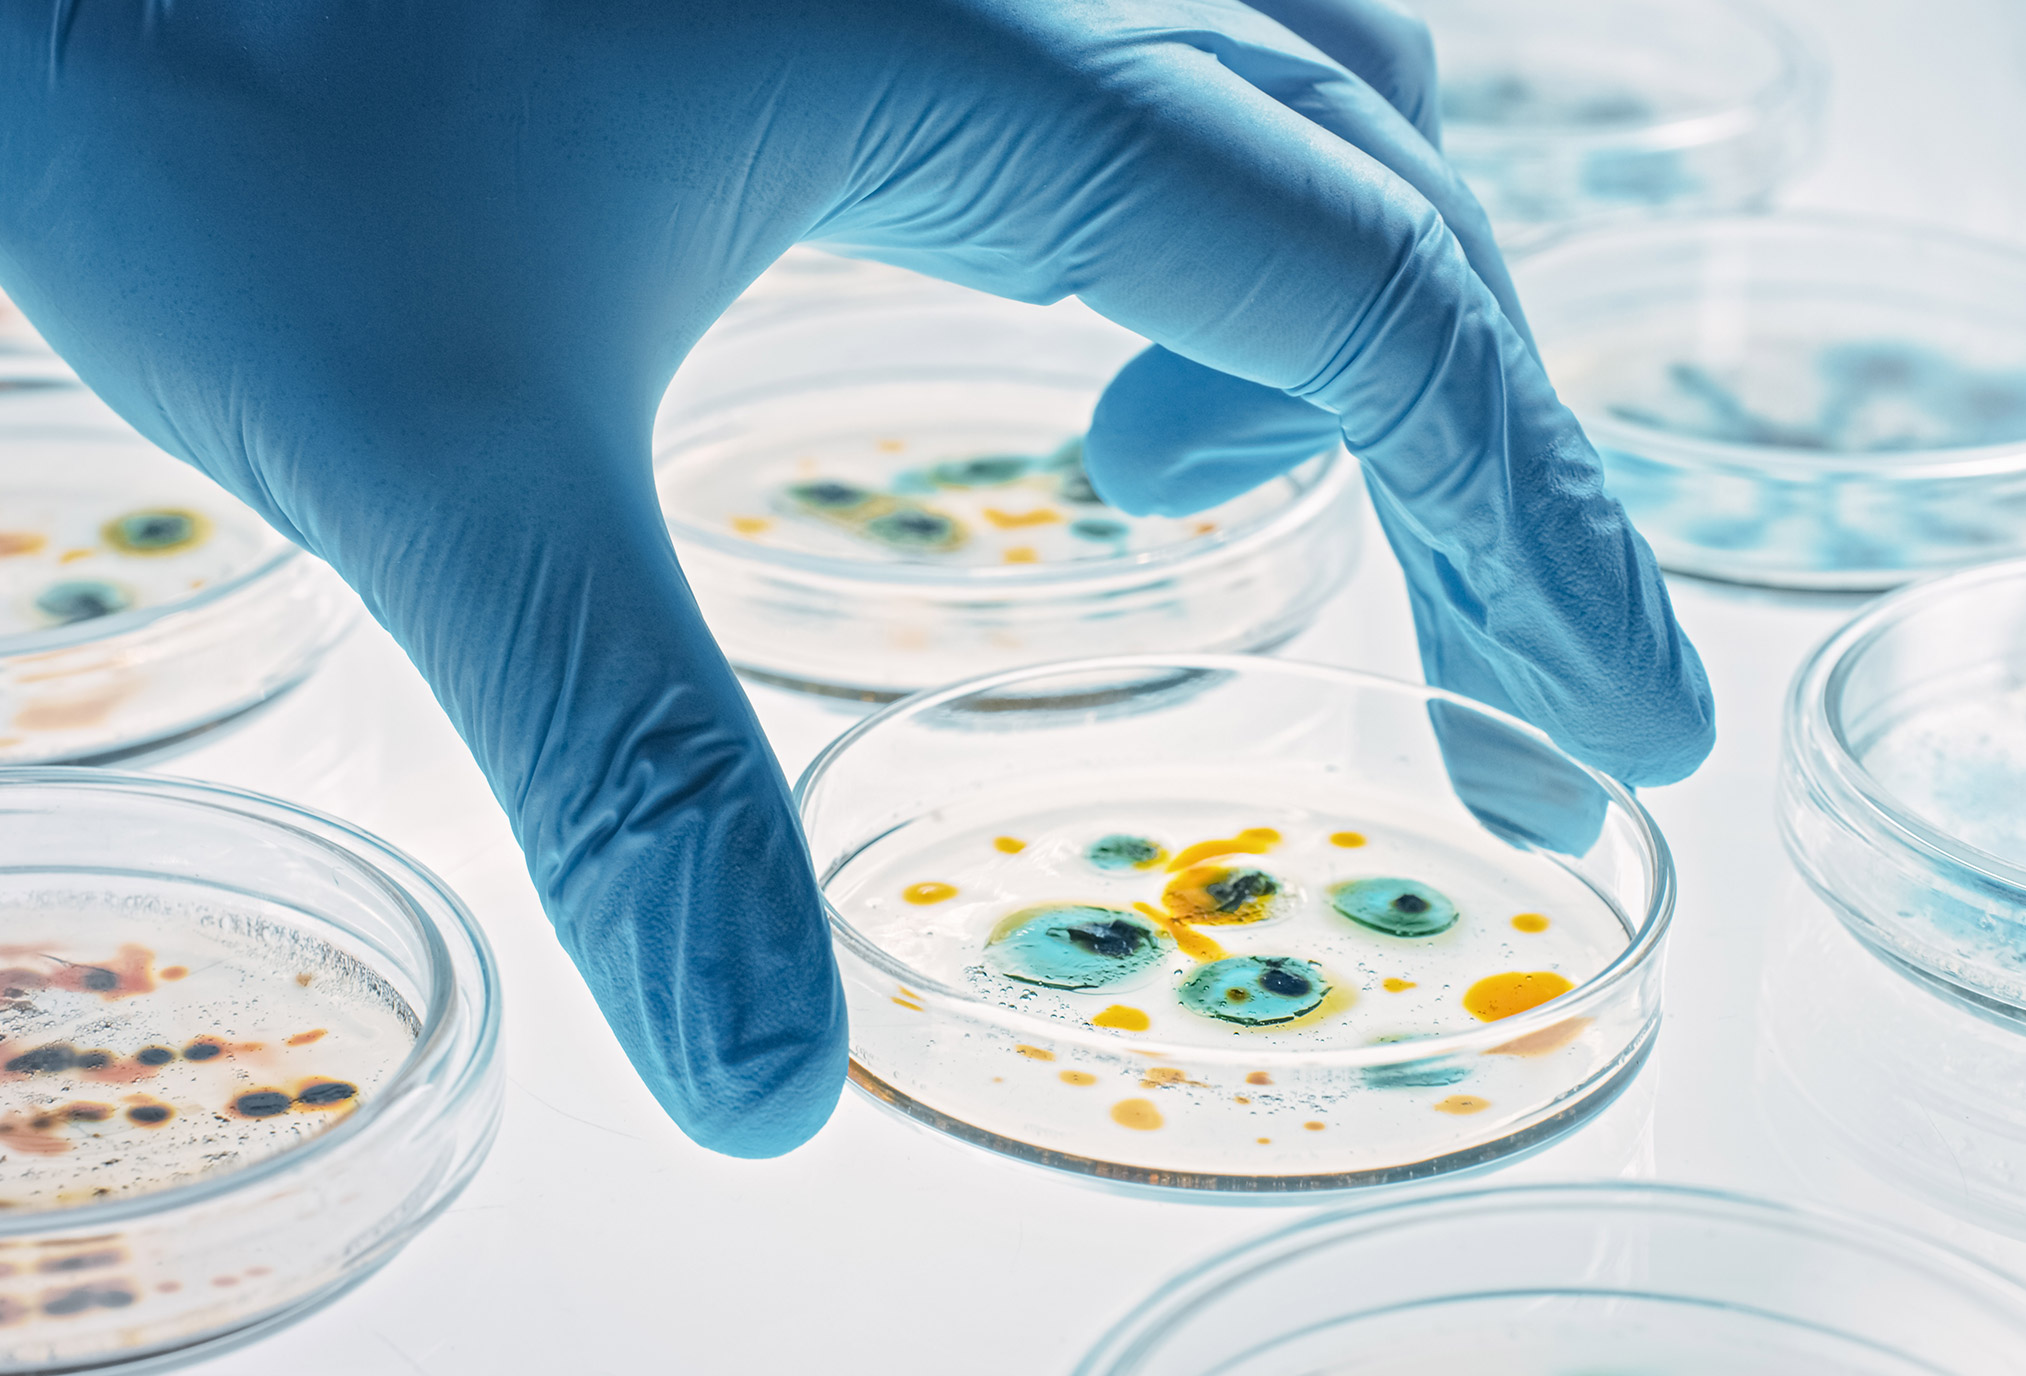

Safe from the Start.
Certified by P2i.
P2i certifies safe baby & pregnancy products
against harmful chemicals and toxics
P2i CERTIFICATION
P2i ensures baby & pregnancy products are carefully screened and free from harmful chemicals, so you can choose confidently.

P2i certifies safe baby & pregnancy products.
At P2i, we believe every family deserves peace of mind. Our seal of approval guarantees that baby and pregnancy products are carefully screened and completely free from the harmful chemicals identified by the International Federation of Gynecology and Obstetrics.
P2i-training physician leaders in the environment and health.
In P2i, we are training clinicians to help patients better understand chemical exposures and their impact on health, from Preconception to Infancy. Physicians receive specialized training on chemicals, their risks, and potential sources of contamination. They learn how to empower patients with knowledge by testing for bioburden and advising on products that are free from harm.

The Science behind P2i
Chemical exposures can be toxic to children: From preconception to infancy and beyond
Endocrine Disrupting Chemicals: Chemicals from our environment can impact our hormones–and all of our bodies’ regulation or development
Developmental origins of disease: Early exposures to toxic chemicals have long-term impacts on our health–and that of the next generation
Epigenetics: Toxic chemical exposures during pregnancy can imprint health for future generations
We base our recommendation on thirty years of research conducted by the National Institute of Health, the National Institute of Environmental Health Science, and the U.S. Environmental Protection Agency.
A Decade of Excellence – Environment and Women’s Health
The Climate Change and Toxic Environmental Exposures Committee joins with Preconception to Infancy in celebrating a decade of FIGO leadership regarding environmental exposures and health.
Saturday, October 4, 2025
8:00 AM – 12:00 PM
The Westin Cape Town
Convention Square, Lower Long Street
Cape Town, 8001

Product Testing

Certification


